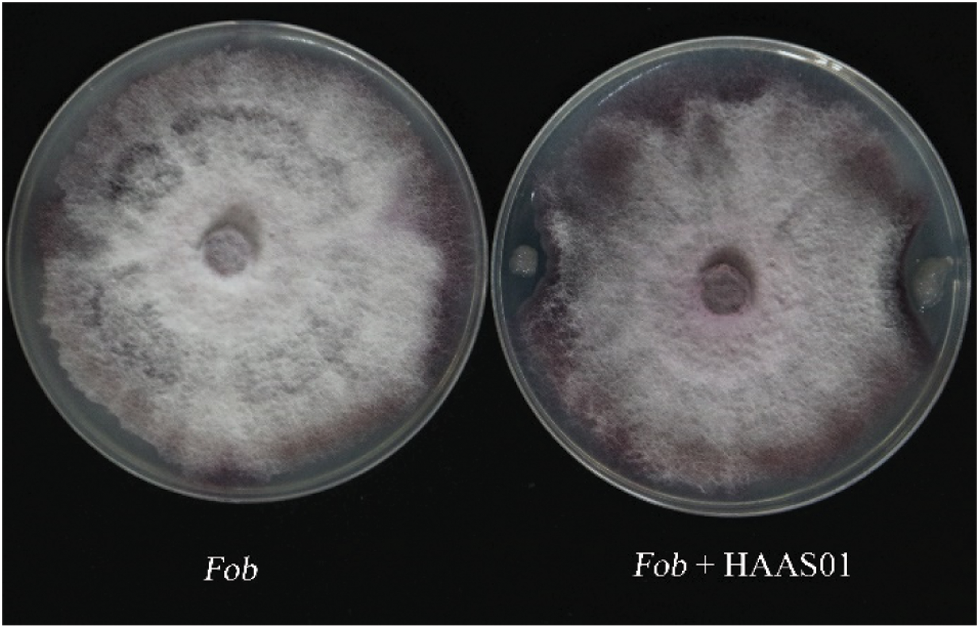
images

![]() | Phyton-International Journal of Experimental Botany | ![]() |
DOI: 10.32604/phyton.2022.020192
ARTICLE
Screening of Bacillus subtilis HAAS01 and Its Biocontrol Effect on Fusarium wilt in Sweet Potato
1Food Crops Institute of Hubei Academy of Agricultural Sciences, Hubei Engineering and Technology Research Center of Sweet Potato, Hubei Key Laboratory of Food Crop Germplasm and Genetic Improvement, Wuhan, 430064, China
2Research Center of Crop Stresses Resistance Technologies, Yangtze University, Jingzhou, 434025, China
*Corresponding Authors: Xinsun Yang. Email: yangxins013@163.com; Wenying Zhang. Email: wyzhang@yangtzeu.edu.cn
#These authors contributed equally to this work
Received: 10 November 2021; Accepted: 06 January 2022
Abstract: Fusarium wilt, a disease caused by Fusarium oxysporum f.sp batatas (Fob) is an important disease in sweet potato production. Using endophytic bacteria for biological control of sweet potato diseases is one of the important ways. A Bacillus subtilis with antagonistic effect on Fusarium wilt of sweet potato was isolated from soil by confrontation culture. According to the biological characteristics, 16S rDNA sequence analysis, and physiological and biochemical analysis, the Bacillus subtilis HAAS01 was named. A pot experiment was conducted for the biological control experiment of strain HAAS01, and the endogenous hormone content, antioxidant enzyme activity, soluble protein content, and related gene expressions of sweet potato plants were detected. The results showed that the HAAS01 strain could promote the production of endogenous hormones and resist the infection of plant diseases together with defensive enzymes and upregulation of related gene expressions. In summary, Bacillus subtilis HAAS01 was effective in controlling Fusarium wilt of sweet potato and has potential for application and development.
Keywords: Bacillus subtilis HAAS01; Ipomoea batatas (L.) Lam.; Fusarium wilt; Fusarium oxysporum f.sp batatas; biological control
Sweet potato (Ipomoea batatas (L.) Lam.), as the seventh-largest food crop in the world, is an important food crop, feed, and industrial raw material [1]. Sweet potato tubers, stems, and leaves contain a lot of starch cellulose and ascorbic acid, and other beneficial nutrients [2]. With the increasing global population and frequent occurrence of natural disasters, sweet potato pests and diseases have been widespread in the world, which seriously threatens the development of the sweet potato industry in various countries and attracts people’s attention [3]. Fusarium wilt is a serious fungal vascular bundle wilt disease with a wide range of incidence. The roots, stems, and petioles of sweet potato plants will crack after infection [4]. At present, sweet potato production mainly relies on chemical pesticides to control the Fusarium wilt of sweet potato. However, the long-term use of chemical pesticides has problems such as resistance of pathogens and environmental pollution, which is not in line with the concept of green agriculture and sustainable development [5].
Recently, researchers have focused on controlling plant-pathogen infections using effective bacteria; in sustainable organic agriculture, biological control has gradually become a very effective method to prevent and control soil-borne diseases. More and more endophytic bacteria are isolated and utilized. In previous studies, Sarwar et al. [6] isolated and identified a bacterial strain A1RT from the soil, and applied it to potato tubers suffering from scab. It was found that the severity of potato tuber disease decreased while the tuber weight and shoot development increased significantly. Durairaj et al. [7] isolated some Bacillus strains from mine tailings and selected a strain with obvious biological control effects on tomatoes infected with Pseudomonas syringe, which can reduce the damage of disease stress on plants and promote plant growth. In addition, 32 strains of endophytic bacteria were isolated from freshly collected pepper seeds, and 6 strains of endophytic bacteria were screened based on Ralstonia solanacearum inhibition assay. Among them, Bacillus subtilis KJ-2 showed the highest biocontrol effect, which promoted the growth of plants [8]. Numerous studies have shown that Bacillus has an obvious effect on the prevention and treatment of plant diseases. The species used as biocontrol bacteria are Bacillus subtilis, Bacillus thuringiensis, Bacillus amyloliquefaciens and Bacillus paenibaci [9]. The Bacillus subtilis isolated worldwide has antibacterial activity, which could inhibit the growth of a variety of plant pathogens; many studies showed that great development potential in biological control [10–12].
The strains of Bacillus subtilis HAAS01 isolated in a previous study in this experiment had a significant inhibitory effect on Fusarium wilt. There are few reports on endogenous hormone and antioxidant enzyme activity in sweet potato Fusarium wilt plants. Thus, the potted plant test was carried out to prove the preventive fungicide effect of Bacillus subtilis HAAS01 strain on sweet potato disease plants. This will contribute to fill relevant research gaps and provide new ideas for better biological control.
2.1 Origin of Tested Strains, Sweet Potato Cultivars
The Bacillus subtilis HAAS01 was isolated from soil by the Hubei Academy of Agricultural Sciences (Wuhan City, Hubei Province, China). In detail, 10 g rhizosphere soil was taken back from the field and diluted with 90 ml sterile water at 30°C, centrifugated at 200 rpm for 30 min, then cultured at 80°C for 20 min; 50 μl soil suspension was cultured on potato dextrose agar medium (PDA, 200 g potato, 15 g agar, 20 g glucose, 1 L water, in natural pH) at 28°C for 3 d. Then, a single colony was selected and preserved at 4°C [13]. Fusarium wilt, a disease caused by Fusarium oxysporum f.sp batatas, was kindly provided from the Xuzhou Sweet Potato Research Center (Xuzhou City, Jiangsu Province, China). The sweet potato cultivar “Eshu 16” was selected as the plant material in this study, which is a new cultivar developed by the Hubei Academy of Agricultural Sciences.
2.2 Dual-Culture Antagonistic Assay
The fungicide activity of Bacillus against Fusarium oxysporum f.sp batatas of sweet potato was determined by confrontation in the dual-culture test. The 5 mm mycelia of Fusarium oxysporum f.sp batatas were inoculated on PDA medium and cultured at 28°C for 4 days. When the pathogen completely colonized the petri dishes, 20 microliters of the overnight culture of isolates were inoculated on the PDA medium, and only Luria-Bertani liquid medium (LB, 10 g Tryptone, 5 g Yeast extract, 10 g NaCl, 1 L water, in natural pH) was added as a control. The plates were incubated at 28°C. Three days later, the zone of inhibition was measured, and the mycelia of fungi from the zone were removed from the plate, and the changes in morphology were observed under the NIKON Ci-L microscope.
2.3 Classification and Identification of Bacillus
The total genomic DNA was extracted using EasyPure® Genomic DNA Kit (TransGen Biotech. Beijing, China) as follows: take Bacillus culture medium 1 ml into a centrifuge tube, 4°C 12000 rpm for 1 min, and the supernatant was removed. 100 μl of Lysis Buffer 2 and 20 μl of Proteinase K were added to the precipitate, and 55°C for 15 min. After 500 μl of Binding Buffer 2 was added at 25°C for 10 min, it was transferred to the centrifuge column at 4°C 12000 rpm for 30 s. Add 500 μl Clean Buffer 2 and Wash Buffer 2 respectively, 4°C 12000 rpm for 30 s. The centrifuged liquid was removed, and 100 μl of Elution Buffer preheated at 65°C was added to the center of the centrifuge column. After standing at 25°C for 1 min, DNA was obtained after centrifugation at 4°C 12000×g for 1 min. The liquid DNA of Bacillus screened was used as the PCR reaction template, The 16S rRNA gene was amplified by PCR using universal primers 27F (5’–AGAGTTTGATCCTGGCTCAG–3’) and 1492R (5’–ACGGCTACCTTGTTACGACTT–3’). The PCR program was as follows: 95°C for 10 min, followed by 34 cycles of 95°C for 30 s, 55°C for 30 s, and 72°C for 60 s, then 72°C for 10 min. PCR products were detected by 1% agarose gel electrophoresis [14]. DNA was recovered and ligated to the vector for sequencing (Aoke Botai Biotech Co., Ltd., Wuhan, China). Then, blast homology analysis by NCBI database (https://blast.ncbi.nlm.nih.gov/Blast.cgi), and construction of the phylogenetic tree of Bacillus strains and other similar strains by the maximum likelihood method in MEGA 6.0.
According to the Bergey’s Manual of Determinative Bacteriology [15], physiological and biochemical identification of the isolated strains was carried out, and the strains were subjected to Gram stain, starch hydrolysis, catalase, anaerobic growth, Voges-Proskauer determination, mannitol acid, glucose acid, nitrate reduction, and indole identification, and whether they can grow in different concentrations of NaCl (w/v) LB liquid medium. Identification by 16S rDNA and physiological and biochemical reactions of the isolates.
2.4 Preparation of Bacillus Suspension
The Bacillus strain was cultured in LB medium at 28°C, 200 rpm for 48 h, and then 5000 rpm for 10 min. Supernatant after precipitation was filtered with bacterial filter membrane (0.22 m), collected the filtered fluid. This filtered fluid was used undiluted and diluted (mixed with sterile water in the same volume) for the pot test.
2.5 Bioassays of Biocontrol, Growth Promotion and Disease Resistance
To further evaluate the biocontrol activity of the HAAS01 strain against Fusarium wilt in plants, a potted plant experiment was conducted. The potted plant test was conducted from July 01 to July 20, 2021, in an artificial climate incubator with 25 ± 2°C, light 10 h dark 14 h alternatively, and 60% relative humidity at the Food Crop Research Institute Laboratory of the Hubei Academy of Agricultural Sciences. For the experiment were selected robust and disease-free sweet potato vines, 20–25 cm in length, with 5–6 spreading leaves. The vine cuttings were planted in a basin of 20 × 20 × 20 cm (depth/top diameter/bottom diameter), containing 300 g of soil mixed with the same quality of zircon, nutrient soil, and fine sand, previously sterilized at 120°C sterilization for 1 h.
The experiment set up four treatments that controlled CK (seedlings initially inoculated with sterile water), Fob (seedlings initially inoculated with Fusarium oxysporum f.sp batatas strain suspension), Fob+1/2H (seedlings initially inoculated with Fusarium oxysporum f.sp batatas, then inoculated with the HAAS01 strain suspension of filtrate diluted twice), and Fob+H (seedlings initially inoculated with Fusarium oxysporum f.sp batatas, then inoculated with the HAAS01 strain suspension of undiluted filtrate). 20 pots were planted per treatment. Seedlings were inoculated and cultured in artificial climate boxes and watered properly. Leaves were collected 5 and 10 days after inoculation. The inoculation methods used in the pot experiments were as follows: the sweet potato stems were immersed in the fresh incision of the Bacillus suspension of filtrate (109 cell⋅ml−1) for 15 min, then taken out and dried. Thereafter, immersed in the Fusarium oxysporum f.sp batatas suspension of filtrate (108 cell⋅ml−1) for 15 min, then taken out and dried, and again immersed in the inactivated Bacillus suspension of filtrate for 15 min, taken out and cut into the pot to complete the inoculation.
2.5.1 Evaluation of Disease Biocontrol
After 10 days of inoculation, the biological control effect of the strain on sweet potato plants was evaluated. The leaf wilt index (LWI) was calculated as follows: leaf wilt index = ∑ (number of plants with a disease scale × value of the corresponding scale)/(total plants rated × the highest scale value) [16]. Biocontrol efficacy was calculated as follows: Biocontrol efficacy = ((LWI of control plants-LWI of treated plants)/disease incidence of control) × 100 [17]. The experiment was divided into three replicates.
2.5.2 Determination of Plant Hormones
Ground 0.1 g leaf samples in liquid nitrogen, added pH 7.4 PBS (phosphate-buffered saline) buffer, at 4°C, 8000 rpm for 30 min, and removed liquid 4°C to preserve. The quantitative determinations of abscisic acid (ABA), gibberellin (GA), jasmonic acid (JA), and salicylic acid (SA) were carried out via an enzyme-linked immunosorbent assay (ELISA) according to Lequin [18].
2.5.3 Determination of Antioxidant Enzyme Activity and Soluble Protein Content
Superoxide dismutase (SOD) and Peroxidase (POD) activities in the supernatant were measured using the following photochemical method. SOD activity was assayed based on the reduction of NBT (nitroblue tetrazolium). POD activity was determined by measuring the absorbance changes at 470 nm. Different treated leaves were collected and separated, 0.25 g sample ground homogenate and homogenized in sodium phosphate buffer (pH 7.8), centrifugated at 4°C, 10,000 rpm for 20 min, and then collected with clear enzyme fluid. Coomassie brilliant blue G-250 method was used to determine soluble protein content [19].
2.6 Expression of Genes Related to Endogenous Hormones and Antioxidant Enzymes Signaling Pathways Analyzed by qRT-PCR
The sequences of gene-specific primers used in the assay are listed in (Table 1). Total RNA was isolated from 50 mg plant tissue by TRlcom Reagent Plant RNA Kit (Tianmo Biotech, TR201, Beijing, China). The first-strand cDNA synthesis was performed using the TransScript® One-Step gDNA Removal and cDNA Synthesis SuperMix (TRANs, Beijing, China). The PCR program was as follows: 94°C for 5 min, followed by 35 cycles of 94°C for 30 s, 55°C for 1 min, and 72°C for 1 min, then 72°C for 10 min.

Figures were created using Microsoft Excel 2019, and all data were processed using the SPSS Statistics 22.0.0.0 software. The maximum likelihood method was using the MEGA 6.06 software. Completely random single factor analysis of variance was used to analyze variance, and two-way ANOVA Duncan’s HSD (honestly significant difference) test was used to detect mean differences at the level P < 0.05.
3.1 Dual-Culture Antagonistic Assay
In this study, overall, 5 endophytic bacteria were extracted from soil, The strains with the suppressive in vitro inhibition against Fusarium oxysporum f.sp batatas pathogen were screened by improving the agar diffusion method. Among them, the most prominent bacteriostatic effect was selected and applied in this study. Fusarium oxysporum f.sp batatas was used as relative control (CK), a Bacillus strain with antagonistic effect against Fusarium oxysporum f.sp batatas was screened by flat confrontation method. Fig. 1 shows the effect of the Bacillus strain against the fungus, with clear inhibition of mycelial growth.
Figure 1: The inhibition of Bacillus subtilis HAAS01 fermentation filtrate on the growth of Fusarium oxysporum f.sp batatas (Fob)
After Fusarium oxysporum f.sp batatas was inhibited by HAAS01, the mycelium edge stopped growing, and the mycelium changed during the confrontation culture. Compared with the normal colony (Fig. 2A), the mycelium growth of the inhibited Fusarium oxysporum f.sp batatas was bent, shortened, and distorted (Fig. 2B).

Figure 2: Morphology of Fusarium oxysporum f.sp batatas mycelium growing normally (A) and inhibited after treatment with Bacillus subtilis HAAS01 (B). a-Mycelial shortening, b-Mycelial disruption and dissolution, c-Terminal enlargement of mycelia
3.2 Identification of Selected Antagonist Strain
The strain was translucent yellow on a PDA medium and slightly dry (Fig. 1). After 16S rDNA PCR amplification, a 1525 bp target band was obtained. Its identity percentage was 100% with other nucleotides in NCBI. Through comparative analysis of 16S rDNA identification characteristics and phylogenetic tree (Fig. 3), it showed the evolutionary relationship between the isolate in our study and other similar strains. The physiological and biochemical characteristics of Bacillus were determined. The results showed that the strain was Gram-positive. Hydrolysis of starch, Catalase, Voges-Proskauer, Nitrate reduction to nitrite, Mannitol acid, and Glucose acid were positive. Anaerobic growth and Indole were negative. The strain could grow in LB liquid medium containing 2%–7% NaCl (w/v) and maintained its activity at 30°C–40°C. Combined with 16S rDNA and biological characteristics observation and physiological and ecological characteristics analysis (Table 2), it was identified and named as Bacillus subtilis HAAS01.

Figure 3: Phylogenetic tree based on 16S rDNA gene sequence by the maximum likelihood method

3.3 Evaluation of Disease Development
On the first day of inoculation strains (fungal pathogen and antagonistic bacteria), the growth status of the four treated sweet potato plants was consistent and developed normally (Fig. 4A). After 5 days, the CK and Fob+1/2H plants grew normally, while Fob and Fob+H treatments of the plant showed partial yellowing (Fig. 4B). Plant growth changed greatly 10 days after inoculation: Fob treatment caused obvious disease, leaves wilted and shed without vigor. However, plants under the other three treatments remained active. Compared with relative CK treatment, the leaf part became yellow under treatments Fob+1/2H and Fob+H, but there was no disease in general (Fig. 4C). It was found that on the 10th day after inoculation, the roots of CK were normal, and there was no absorption root formation in Fob, while there was less absorption root formation in Fob+1/2H and Fob+H treatments. Fob+1/2H formed more absorbing roots than Fob+H treatment (Fig. 4D). On the 10th day of inoculation, the biocontrol ability of Bacillus was evaluated. The results showed that the leaf wilt index (LWI) of plants inoculated with Fusarium oxysporum f.sp batatas. Fusarium wilt was 82.50. For plants inoculated with different concentrations of Bacillus, the control effect of the Fob+1/2H treatment on Fusarium oxysporum f.sp batatas was 70.00%, while that of the Fob+H treatment was 62.5%.

Figure 4: Control effect of HAAS01 on Fusarium oxysporum f.sp batatas (Fob) in plants at 1 (A), 5 (B), and 10(C) days after inoculation with fungal pathogens; whole plant morphology after 10 days of inoculation (D). CK: seedlings initially inoculated with sterile water, Fob: seedlings initially inoculated with Fusarium oxysporum f.sp batatas strain suspension, Fob+1/2H: seedlings initially inoculated with Fusarium oxysporum f.sp batatas, then inoculated with HAAS01 strain suspension of filtrate diluted twice, Fob+H: seedlings initially inoculated with Fusarium oxysporum f.sp batatas, then inoculated with HAAS01 strain suspension of undiluted filtrate
3.4 The Endogenous Hormone Content Levels
Plant endogenous hormones were the main factors that affected plant growth and development. Measurement of ABA, GA, JA, and SA in sweet potato leaves under various treatments showed that, compared to the control on the 5th day, the ABA content in the Fob treatment was enhanced, while Fob+1/2H and Fob+H treatments presented the opposite effects–the ABA content decreased in response to the endophyte HAAS01. Then on the 10th day, ABA content in different treatments increased, but the differences between treatments remained unchanged. The GA content was highest in CK and lowest in the Fob treatment on the 5th day. With the extension of the growth period, except for the decrease of GA content on leaves of sweet potato plants under the Fob treatment, the other treatments increased, but the differences remained unchanged in general. In the whole growth period, JA and SA contents were the highest under the Fob+1/2H treatment, followed by the Fob+H treatment, and the CK content was the lowest in the control group (Table 3).

Different lower-case letters in each column indicate significant differences between different treatments in the same period (P < 0.05). DAT: days after transplanting, CK: seedlings initially inoculated with sterile water, Fob: seedlings initially inoculated with Fusarium oxysporum f.sp batatas strain suspension, Fob+1/2H: seedlings initially inoculated with Fusarium oxysporum f.sp batatas, then inoculated with HAAS01 strain suspension of filtrate diluted twice, Fob+H: seedlings initially inoculated with Fusarium oxysporum f.sp batatas, then inoculated with HAAS01 strain suspension of undiluted filtrate.
3.5 Antioxidant Enzyme Activity and Soluble Protein Content Levels
As important enzymes in the antioxidant enzyme system, SOD and POD activities were significantly different among different treatments. From the 5th to the 10th day, the SOD activities of the four treatments all increased with the highest SOD activity under the Fob+1/2H treatment, followed by Fob+H and Fob treatments, and the lowest SOD activity under the CK treatment. However, it was found that with the development of the growth period, except for the decrease of POD activity under the Fob treatment, the enzyme activity of the other treatments increased. In the determination of soluble proteins in leaves, it was found that only the Fob treatment had the lowest soluble protein content and decreased significantly, while the other treatments did not change significantly. The soluble protein content of CK was the highest (Table 4).

Different lower-case letters in each column indicate significant differences between different treatments in the same period (P < 0.05). DAT: Days after transplanting, CK: seedlings initially inoculated with sterile water, Fob: seedlings initially inoculated with Fusarium oxysporum f.sp batatas strain suspension, Fob+1/2H: seedlings initially inoculated with Fusarium oxysporum f.sp batatas, then inoculated with HAAS01 strain suspension of filtrate diluted twice, Fob+H: seedlings initially inoculated with Fusarium oxysporum f.sp batatas, then inoculated with HAAS01 strain suspension of undiluted filtrate.
3.6 Gene Expression Related to Endogenous Hormones and Antioxidant Enzymes Signaling Pathway Analysis by qRT-PCR on Day 5 and 10
In gene expression related to endogenous hormone biosynthesis and signaling pathways (Fig. 5), there was no significant difference between IbNCED and IbGA20ox gene expression under four treatments. Compared with the control, the expression of the IbNCED gene under the Fob treatment was the highest. In the whole period, the expression level of the IbGA20ox gene under the Fob treatment was the lowest; the Fob+1/2H and Fob+H treatments down-regulated the IbGA20ox gene expression compared with CK. There were significant differences in gene expression of IbMYC2 and IbPR1 between different treatments. The Fob+1/2H and Fob+H treatments both promoted IbMYC2 and IbPR1 up-regulation, and the up-regulation of IbMYC2 was greater than that of IbPR1. On the 5th day after transplanting, the expression levels of IbMYC2 and IbPR1 genes under the Fob+1/2H treatment were significantly higher than those under other treatments. Compared with the control, the expression of IbMYC2 and IbPR1 under the Fob+1/2H treatment was at a high level on the 10th day. Two antioxidant enzyme genes expression analyses by qRT-PCR, the expression of IbSOD gene was significantly different under different treatments on day 5 and 10; comparing the CK, the Fob+1/2H treatments, up-regulated the IbSOD gene expression in sweet potato. On day 5, there were significant differences in IbPOD gene expression among different treatments, but there was no significant difference on day 10; Compared with the control, the other three treatments increased the expression of the IbPOD gene, and the expression level of the Fob treatment was the highest on the 5th day, and the expression level of the Fob+1/2H treatment was the highest on the 10th day.

Figure 5: Relative expression levels of genes related to ABA (IbNCED), GA (IbGA20ox), JA (IbMYC2), SA (IbPR1), SOD (IbSOD), and POD (IbPOD) signaling pathways in sweet potato analyzed by qRT-PCR at 5 and 10 days post irrigation with fungal pathogens. Different lower-case letters above each histogram indicate significant differences between different treatments in the same period (P < 0.05). DAT: days after transplanting, CK: seedlings initially inoculated with sterile water, Fob: seedlings initially inoculated with Fusarium oxysporum f.sp batatas strain suspension, Fob+1/2H: seedlings initially inoculated with Fusarium oxysporum f.sp batatas, then inoculated with HAAS01 strain suspension of filtrate diluted twice, Fob+H: seedlings initially inoculated with Fusarium oxysporum f.sp batatas, then inoculated with HAAS01 strain suspension of undiluted filtrate
Bacillus subtilis is one of the main growth-promoting bacteria in the plant rhizosphere [10]. It dissolves minerals, competes with pathogens for nutrition and infects spatial sites, secretes antimicrobial substances [20], improves microbial community structure in the plant-rhizosphere soil, and induces plant hormone release. To promote plant development, it enhances plant disease resistance, and limits resistance to pathogen damage to plants [12,21]. It is reported that a Bacillus subtilis HK-CSM-1 isolated from the rhizosphere of plants has an effective control on Panax ginseng. When ginseng is inoculated with this strain, the number of pathogens in the plant is significantly reduced [22]. An endophyte strain named B21 was isolated from Osmanthus fragrans Lour; the culture filtrate showed antifungal activity against Magnaporthe oryzae which causes rice blast disease [23]. Our study proved for the first time that Bacillus subtilis HAAS01 is an effective bacillus, which can promote plant resistance to Fusarium wilt by inhibiting Fusarium oxysporum f.sp batatas.
As one of the most influential fungal diseases in the growth of the sweet potato, the Fusarium wilt pathogen can destroy the membrane system of sweet potato roots, resulting in metabolic disorders, thereby inhibiting the absorption and transportation of root cell nutrients and water, negatively affecting root development [24]. The roots, stems, and petioles of sweet potato plants split, and this situation usually occurs in parts close to the ground [25] and leaves fall off obviously [26,27]. Moreover, studies have shown that the isolated Bacillus has an obvious control effect on Fusarium oxysporum f.sp batatas in sweet potato [4]. Meanwhile, our pot trial assay showed that plants infected with Fusarium wilt pathogen almost had no absorption root formation and stem vines were dehiscent. The incomplete development of absorption roots harmed the absorption, synthesis, and transportation of nutrients, resulting in withering and falling of many leaves and growth stagnation. However, the disease condition of the diseased plants inoculated with Bacillus subtilis HAAS01 was significantly improved, more absorbing roots appeared, and the stems were not cracked. To our surprise, the growth status of the plants in treatment Fob+1/2H was better than that in Fob+H. Therefore, we speculated that a low concentration of Bacillus subtilis HAAS01 may have a better control effect on Fusarium wilt, and further research is needed.
Infection of host plants by pathogenic fungi can cause changes in plant endogenous hormone content [11]. ABA is known as the stress hormone [28], and GA is the key hormone to promote cell elongation and growth [29,30]. It was reported that Botrytis cinerea can increase endogenous ABA content and ethylene release in grape tissues [31]. The ABA content of tomato significantly increased after infection with Verticillium alboatrum [32]. In this study, the ABA content of the four treatments increased, but the ABA content of the plants inoculated with HAAS01 maintained a low level. Except that the GA content of Fob treatment decreased with the growth period, the other treatments all increased. These findings are consistent with other reports [31,32]. With the invasion of pathogens, plants can make an active response to pathogen stress by jasmonic acid signaling [33]. The JA content was induced to increase after Fusarium wilt invaded plants. After inoculation with HAAS01, the JA content continued to increase, which was significantly higher than that of CK and Fob treatments. High levels of JA largely slowed down the invasion of Fusarium wilt. Salicylic acid plays an important role in the signaling pathway of the plant defense response [34]. In transgenic crops, reducing salicylic acid levels affects plant sensitivity to fungi [35]. In this study, the SA content on the 10th day was higher than that on the 5th day. Compared with the control, the SA content of plants inoculated with Fusarium oxysporum f.sp batatas and HAAS01 increased, and the content on the Fob+1/2H treatment was the highest. It is reported that after pathogen infection, SA in plants will accumulate in large quantities to increase the resistance of plants to pathogen infection [36]. This also confirmed that the HAAS01 strain can improve the diseased plants’ ability.
Disease resistance is not only related to antagonistic substances produced by the biocontrol bacteria but is closely related to the defense enzyme system [37]. The activities of SOD and POD and the content of soluble proteins involved in physiological and metabolic activities in plants reflect the degree of stress in plants [38]. The increased enzyme activity and protein content hinder the transmission of pathogens, thereby maintaining the balance of the active oxygen system, which was an important indicator for the tested plant resistance [39,40]. Our result in the present study showed that increased SOD and POD activities in the four treatments improved disease resistance, with the Fob+1/2H treatment showing the highest increase in SOD and POD activities. Except that the soluble protein content of CK increased with the growth period, the other treatments all decreased, among which the Fob treatment decreased the most, while the soluble protein content of the HAAS01 treatment maintained a high and stable level. The study is similar to others [38,39]. Preliminary analysis showed that the HAAS01 strain enhanced the defense system enzymes and increased osmotic adjustment substances to enhance the water retention ability of cells. It positively regulated the growth and development of diseased plants by affecting the activity of antioxidant enzymes in sweet potato leaves.
Previous and recent studies on transgenic plants have clearly shown that the transcriptional regulation of NCEDs [41], GA20ox [42], MYC2 [43], and PR1 [44] plays an important role in plant immune responses. To our surprise, the IbNCED and IbGA20ox gene expression in the seedlings pretreated with HAAS01 did not completely greater than in seedlings inoculated with distilled water and pathogen-infected alone. The IbNCED and IbGA20ox genes were involved in the ABA and GA signaling pathway by HAAS01, respectively, indicating their important role in bacterium interactions. The expression of the IbMYC2 gene was up-regulated after plant inoculation with Fusarium wilt and HAAS01. At the same time, the IbPR1 gene was also up-regulated after infection of HAAS01-pretreated plants with Fusarium wilt. This is consistent with previous reports [45,46], indicating that IbMYC2 and IbPR1 genes were activated by pathogens in sweet potato to induce up-regulation of gene expression. On this basis, the gene expression was up-regulated to varying degrees after inoculation with HAAS01, and the synthesis of the endogenous hormones JA and SA was stimulated. Similarly, we observed up-regulated expression of the IbSOD and IbPOD genes, but without a concomitant increase in POD enzyme activity levels. One possible explanation could be that SOD and POD signaling pathways interact antagonistically or positively [47,48]. Further studies will enable us to better understand the correlation between the relevant indicators caused by the signal transduction process.
Bacillus subtilis HAAS01 was a biocontrol strain isolated from rhizosphere soil of plants and identified as Bacillus subtilis by analysis of its 16S rDNA gene sequence and its biochemical and physiological characteristics. In the potted pathogenic test, it was observed that plants inoculated with HAAS01 spore suspension could promote the formation of more absorbing roots and alleviate the symptoms of stem cracking, promote the production of the endogenous hormones GA, JA, and SA, and jointly resist the infection of plant diseases under the joint action of the defensive enzymes SOD and POD. In addition, with the increase of the hormone content and enzyme activities, the expression levels of related regulatory genes IbMYC2, IbPR1, IbSOD, and IbPOD were significantly up-regulated. This indicated that the basal defense response can be stimulated and induce plant resistance. This study is the first report regarding Bacillus subtilis HAAS01 biocontrol potential against Fusarium wilt in sweet potato, thus playing a preventive role, with the potential as a plant fungicide and could be used for commercial exploration.
Acknowledgement: We especially thank the Xuzhou Sweet Potato Research Center, for sharing the pathogen of the Fusarium wilt in sweet potato.
Data Availability Statement: The authors confirm that the data supporting the findings of this study are available within the article and its supplementary materials.
Funding Statement: This work was supported by the National Key R&D Program of China, 2019YFD1001300 and 2019YFD1001305; China Agriculture Research System of MOF and MARA, China.
Conflicts of Interest: The authors declare that they have no conflicts of interest to report regarding the present study.
1. Liu, Q. C. (2017). Improvement for agronomically important traits by gene engineering in sweetpotato. Breeding Science, 67(1), 15–26. DOI 10.1270/jsbbs.16126. [Google Scholar] [CrossRef]
2. Amagloh, F. C., Yada, B., Tumuhimbise, G. A., Amagloh, F. K., Kaaya, A. N. (2021). The potential of sweet potato as a functional food in Sub-saharan Africa and its implications for health: A review. Molecules, 26(10), 2971. DOI 10.3390/molecules26102971. [Google Scholar] [CrossRef]
3. Kreuze, J. F., Valkonen, J. P. (2017). Utilization of engineered resistance to viruses in crops of the developing world, with emphasis on sub-saharan Africa. Current Opinion in Virology, 26, 90–97. DOI 10.1016/j.coviro.2017.07.022. [Google Scholar] [CrossRef]
4. Ogawa, K., Komada, H. (1984). Biological control of Fusarium wilt of sweet potato by non-pathogenic Fusarium oxysporum. Japanese Journal of Phytopathology, 50(1), 1–9. DOI 10.3186/jjphytopath.50.1. [Google Scholar] [CrossRef]
5. Kim, M. J., Shim, C. K., Ko, B. G., Kim, J. (2020). Effect of the microalga Chlorella fusca CHK0059 on strawberry PGPR and biological control of Fusarium wilt disease in non-pesticide hydroponic strawberry cultivation. Journal of Microbiology Biotechnology, 30(5), 708–716. DOI 10.4014/jmb.2001.01015. [Google Scholar] [CrossRef]
6. Sarwar, A., Latif, Z., Zhang, S., Zhu, J., Zechel, D. L. et al. (2018). Biological control of potato common scab with rare isatropolone c compound produced by plant growth promoting Streptomyces A1RT. Frontiers in Microbiology, 9, 1126. DOI 10.3389/fmicb.2018.01126. [Google Scholar] [CrossRef]
7. Durairaj, K., Velmurugan, P., Park, J. H., Chang, W. S., Park, Y. J. et al. (2018). Characterization and assessment of two biocontrol bacteria against Pseudomonas syringae wilt in Solanum lycopersicum and its genetic responses. Microbiological Research, 206, 43–49. DOI 10.1016/j.micres.2017.09.003. [Google Scholar] [CrossRef]
8. Dowarah, B., Agarwal, H., Krishnatreya, D. B., Sharma, P. L., Kalita, N. et al. (2021). Evaluation of seed associated endophytic bacteria from tolerant chilli cv. Firingi Jolokia for their biocontrol potential against bacterial wilt disease. Microbiological Research, 248, 126751. DOI 10.1016/j.micres.2021.126751. [Google Scholar] [CrossRef]
9. Shafi, J., Tian, H., Ji, M. S. (2017). Bacillus species as versatile weapons for plant pathogens: A review. Biotechnology and Biotechnological Equipment, 31(3), 446–459. DOI 10.1080/13102818.2017.1286950. [Google Scholar] [CrossRef]
10. Earl, A. M., Losick, R., Kolter, R. (2008). Ecology and genomics of Bacillus subtilis. Trends in Microbiology, 16(6), 269–75. DOI 10.1016/j.tim.2008.03.004. [Google Scholar] [CrossRef]
11. Tahir, H. A. S., Gu, Q., Wu, H. J., Raza, W., Hanif, A. et al. (2017). Plant growth promotion by volatile organic compounds produced by Bacillus subtilis SYST2. Frontiers Microbiology, 8, 171, e48744. DOI 10.3389/fmicb.2017.00171. [Google Scholar] [CrossRef]
12. Duanis-Assaf, D., Steinberg, D., Shemesh, M. (2020). Efficiency of Bacillus subtilis metabolism of sugar alcohols governs its probiotic effect against cariogenic Streptococcus mutans. Artificial Cells, Nanomedicine, and Biotechnology, 48(1), 1222–1230. DOI 10.1080/21691401.2020.1822855. [Google Scholar] [CrossRef]
13. Nath, S., Deb, B., Sharma, I. (2018). Isolation of toxic metal-tolerant bacteria from soil and examination of their bioaugmentation potentiality by pot studies in cadmium- and lead-contaminated soil. International Microbiology, 21(1–2), 35–45. DOI 10.1007/s10123-018-0003-4. [Google Scholar] [CrossRef]
14. Lee, P. Y., Costumbrado, J., Hsu, C. Y., Kim, Y. H. (2012). Agarose gel electrophoresis for the separation of DNA fragments. Journal of Visualized Experiments, (623923. DOI 10.3791/3923. [Google Scholar] [CrossRef]
15. Buchanan, R., Gibbons, N. E., Bergey (1975). Bergey’s manual of determinative bacteriology. Taxon, 24(2/3), 377. DOI 10.2307/1218353. [Google Scholar] [CrossRef]
16. Fasina, K. A., Adesetan, T. O., Oseghale, F., Egberongbe, H. O., Aghughu, O. O. et al. (2020). Bacteriological and phytochemical assessment of Ficus asperifolia linn. infusion. Biomed Research International, 2020, 9762639. DOI 10.1155/2020/9762639. [Google Scholar] [CrossRef]
17. Sherzad, Z., Canming, T. (2020). A new strain of Bacillus velezensis as a bioagent against Verticillium dahliae in cotton: Isolation and molecular identification. Egyptian Journal of Biological Pest Control, 30(1), 118. DOI 10.1186/s41938-020-00308-y. [Google Scholar] [CrossRef]
18. Lequin, R. M. (2005). Enzyme immunoassay (EIA)/enzyme-linked immunosorbent assay (ELISA). Clinical Chemistry, 51(12), 2415–2418. DOI 10.1373/clinchem.2005.051532. [Google Scholar] [CrossRef]
19. Grintzalis, K., Georgiou, C. D., Schneider, Y. J. (2015). An accurate and sensitive Coomassie Brilliant Blue G-250-based assay for protein determination. Analytical Biochemistry, 480, 28–30. DOI 10.1016/j.ab.2015.03.024. [Google Scholar] [CrossRef]
20. Santos, R. M., Kandasamy, S., Rigobelo, E. C. (2018). Sugarcane growth and nutrition levels are differentially affected by the application of PGPR and cane waste. Microbiologyopen, 7(6), e00617. DOI 10.1002/mbo3.617. [Google Scholar] [CrossRef]
21. Beneduzi, A., Ambrosini, A., Passaglia, L. M. P. (2012). Plant growth-promoting rhizobacteria (PGPRTheir potential as antagonists and biocontrol agents. Genetics and Molecular Biology, 35(4 suppl 1), 1044–1051. DOI 10.1590/s1415-47572012000600020. [Google Scholar] [CrossRef]
22. Ryu, H., Park, H., Suh, D. S., Jung, G. H., Park, K. et al. (2014). Biological control of Colletotrichum panacicola on panax ginseng by Bacillus subtilis HK-CSM-1. Journal of Ginseng Research, 38(3), 215–219. DOI 10.1016/j.jgr.2014.05.001. [Google Scholar] [CrossRef]
23. Rong, S. H., Xu, H., Li, L. H., Chen, R. J., Gao, X. L. et al. (2020). Antifungal activity of endophytic Bacillus safensis B21 and its potential application as a biopesticide to control rice blast. Pesticide Biochemistry and Physiology, 162, 69–77. DOI 10.1016/j.pestbp.2019.09.003. [Google Scholar] [CrossRef]
24. Sun, Y. M., Li, Y. R., Wang, M., Wang, C. Z., Ling, N. et al. (2018). Redox imbalance contributed differently to membrane damage of cucumber leaves under water stress and Fusarium infection. Plant Science, 274, 171–180. DOI 10.1016/j.plantsci.2018.05.025. [Google Scholar] [CrossRef]
25. Gordon, T. R. (2017). Fusarium oxysporum and the Fusarium wilt syndrome. Annual Review of Phytopathology, 55, 23–39. DOI 10.1146/annurev-phyto-080615-095919. [Google Scholar] [CrossRef]
26. Michielse, C. B., Rep, M. (2009). Pathogen profile update: Fusarium oxysporum. Molecular Plant Pathology, 10(3), 311–24. DOI 10.1111/j.1364-3703.2009.00538.x. [Google Scholar] [CrossRef]
27. Kabashnikova, L., Abramchik, L., Domanskaya, I., Savchenko, G., Shpileuski, S. (2020). Β-1, 3-glucan effect on the photosynthetic apparatus and oxidative stress parameters of tomato leaves under Fusarium wilt. Functional Plant Biology, 47(11), 988–997. DOI 10.1071/FP19338. [Google Scholar] [CrossRef]
28. Larkindale, J., Knight, M. R. (2002). Protection against heat stress-induced oxidative damage in arabidopsis involves calcium, abscisic acid, ethylene, and salicylic acid. Plant Physiology, 128(2), 682–695. DOI 10.1104/pp.010320. [Google Scholar] [CrossRef]
29. Hartweck, L. M. (2008). Gibberellin signaling. Planta, 229(1), 1–13. DOI 10.1007/s00425-008-0830-1. [Google Scholar] [CrossRef]
30. Hedden, P., Thomas, S. G. (2012). Gibberellin biosynthesis and its regulation. Biochemical Journal, 444(1), 11–25. DOI 10.1042/BJ20120245. [Google Scholar] [CrossRef]
31. AbuQamar, S. F., Moustafa, K., Tran, L. S. (2016). ‘Omics’ and plant responses to Botrytis cinerea. Frontiers in Plant Science, 7, 1658. DOI 10.3389/fpls.2016.01658. [Google Scholar] [CrossRef]
32. Pegg, G. F., Cronshaw, D. K. (1976). Ethylene production in tomato plants infected with Verticillium albo-atrum. Physiological Plant Pathology, 8(3), 279–295. DOI 10.1016/0048-4059(76)90022-9. [Google Scholar] [CrossRef]
33. Wasternack, C., Song, S. S. (2017). Jasmonates: Biosynthesis, metabolism, and signaling by proteins activating and repressing transcription. Journal of Experimental Botany, 68(6), 1303–1321. DOI 10.1093/jxb/erw443. [Google Scholar] [CrossRef]
34. Govrin, E. M., Levine, A. (2000). The hypersensitive response facilitates plant infection by the necrotrophic pathogen Botrytis cinerea. Current Biology, 10(13), 751–757. DOI 10.1016/s0960-9822(00)00560-1. [Google Scholar] [CrossRef]
35. Delaney, T. P., Uknes, S., Vernooij, B., Friedrich, L., Weymann, K. et al. (1994). A central role of salicylic acid in plant disease resistance. Science, 266(5188), 1247–1250. DOI 10.1126/science.266.5188.1247. [Google Scholar] [CrossRef]
36. Shah, J. (2003). The salicylic acid loop in plant defense. Current Opinion in Plant Biology, 6(4), 365–371. DOI 10.1016/s1369-5266(03)00058-x. [Google Scholar] [CrossRef]
37. Ali, S., Huang, Z., Li, H. X., Bashir, M. H., Ren, S. X. (2013). Antioxidant enzyme influences germination, stress tolerance, and virulence of Isaria fumosorosea. Journal of Basic Microbiology, 53(6), 489–497. DOI 10.1002/jobm.201100645. [Google Scholar] [CrossRef]
38. Batool, T., Ali, S., Seleiman, M. F., Naveed, N. H., Ali, A. et al. (2020). Plant growth promoting rhizobacteria alleviates drought stress in potato in response to suppressive oxidative stress and antioxidant enzymes activities. Scientific Reports, 10(1), 16975. DOI 10.1038/s41598-020-73489-z. [Google Scholar] [CrossRef]
39. Ge, H. L., Liu, Z. H. (2020). Alleviation of tetrabromobisphenol A toxicity in soybean seedlings by Rhodopseudomonas palustris RP1n1. Archives of Microbiology, 202(4), 895–903. DOI 10.1007/s00203-019-01797-8. [Google Scholar] [CrossRef]
40. Halifu, S., Deng, X., Song, X. S., Song, R. Q., Liang, X. (2020). Inhibitory mechanism of Trichoderma virens ZT05 on Rhizoctonia solani. Plants, 9(7), 912. DOI 10.3390/plants9070912. [Google Scholar] [CrossRef]
41. Qin, X., Zeevaart, J. A. D. (2002). Overexpression of a 9-cis-epoxycarotenoid dioxygenase gene in Nicotiana plumbaginifolia increases abscisic acid and phaseic acid levels and enhances drought tolerance. Plant Physiology, 128(2), 544–551. DOI 10.1104/pp.010663. [Google Scholar] [CrossRef]
42. Fukazawa, J., Teramura, H., Murakoshi, S., Nasuno, K., Nishida, N. et al. (2014). DELLAs function as coactivators of GAI-ASSOCIATED FACTOR1 in regulation of gibberellin homeostasis and signaling in arabidopsis. Plant Cell, 26(7), 2920–38. DOI 10.1105/tpc.114.125690. [Google Scholar] [CrossRef]
43. Zhang, C. P., Lei, Y. T., Lu, C. K., Wang, L., Wu, J. Q. (2020). MYC2, MYC3, and MYC4 function additively in wounding-induced jasmonic acid biosynthesis and catabolism. Journal of Integrative Plant Biology, 62(8), 1159–1175. DOI 10.1111/jipb.12902. [Google Scholar] [CrossRef]
44. Ren, R., Wei, Y. L., Ahmad, S., Jin, J. P., Gao, J. et al. (2020). Identification and characterization of NPR1 and PR1 homologs in Cymbidium orchids in response to multiple hormones, salinity and viral stresses. International Journal of Molecular Sciences, 21(6), 1977. DOI 10.3390/ijms21061977. [Google Scholar] [CrossRef]
45. Wang, C. J., Wang, Y. Z., Chu, Z. H., Wang, P. S., Liu, B. Y. et al. (2020). Endophytic Bacillus amyloliquefaciens YTB1407 elicits resistance against two fungal pathogens in sweet potato (Ipomoea batatas (L.) Lam.). Journal of Plant Physiology, 253, 153260. DOI 10.1016/j.jplph.2020.153260. [Google Scholar] [CrossRef]
46. Zhang, H., Zhang, Q., Zhai, H., Gao, S. P., Yang, L. et al. (2020). IbBBX24 promotes the jasmonic acid pathway and enhances Fusarium wilt resistance in sweet potato. Plant Cell, 32(4), 1102–1123. DOI 10.1105/tpc.19.00641. [Google Scholar] [CrossRef]
47. Chai, L. L., Yang, L., Zhang, Y. Z., Zhou, Y. H., Wang, F. et al. (2020). Antagonism or synergism? responses of Hydrocharis dubia (Bl.) Backer to linear alkylbenzene sulfonate, naphthalene and their joint exposure. Ecotoxicology and Environmental Safety, 200, 110747. DOI 10.1016/j.ecoenv.2020.110747. [Google Scholar] [CrossRef]
48. Liu, J., Wang, X. M., Yang, L., Nan, W. B., Ruan, M. J. et al. (2020). Involvement of active MKK9-MAPK3/MAPK6 in increasing respiration in salt-treated Arabidopsis callus. Protoplasma, 257(3), 965–977. DOI 10.1007/s00709-020-01483-3. [Google Scholar] [CrossRef]
![]() | This work is licensed under a Creative Commons Attribution 4.0 International License, which permits unrestricted use, distribution, and reproduction in any medium, provided the original work is properly cited. |